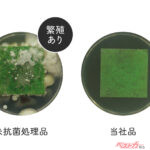

今年ももう梅雨の季節……エアコンの臭いが気になる……なんて時は、エアコンフィルターの交換も効果的。デンソーの「クリーンエアフィルター」は防菌、防カビ効果があるので梅雨の時期は特に頼もしい存在なのだ!
文:ベストカーWeb編集部/写真:デンソー
デンソー(DENSO) カーエアコン用フィルター クリーンエアフィルター DCC3008 (014535-2220) 高除塵 PM2.5対…
■2層の除塵フィルターで高い性能を実現
デンソーの「クリーンエアフィルター」は、帯電不織布ろ材の採用により、高い除塵性能を実現。エアコン稼働時にチリ・ホコリのほか、スギやヒノキなどの花粉をフィルターでキャッチ。
※空気中の有害物質のすべてを除去できるものではありません。
■フィルタ―に付着した菌・カビの繁殖を減少
緑色の層(クリーンエアフィルターの場合。クリーンエアフィルター プレミアムの場合は黄色の層になります)に抗菌剤を採用し、フィルターに付着した菌・カビの繁殖を減少させ、繁殖を防ぐ!
※試験室での試験であり、 実車での試験ではありません。 効果は環境、使用時間、条件により異なります。
■PM2.5や花粉もキャッチ!
大気中に浮遊している2.5μm 以下の小さな粒子、「PM2.5」や花粉などを大幅に除去。
■現在「クリーンエアフィルター」「クリーンエアフィルター プレミアム」の2種類が展開中!
現在デンソーからは、「クリーンエアフィルター」「クリーンエアフィルター プレミアム」の2種類が展開中だ。たとえば「クリーンエアフィルター」は「ペット臭」の脱臭は不可、などできることが違うので、用途に合わせて選んでほしい。またデンソーのホームページでは車種ごとの交換の目安のなどが検索できるので、そちらも是非参考にしてみよう。
●「クリーンエアフィルター」の使用用途
◎高除塵
◎脱臭(排ガス)
×脱臭(ペット臭)
◎脱臭(食事臭)
◎抗菌・防カビ
◎抗ウイルス
◎安定風量
×ビタミンC放出
×各種由来たんぱく質の減少
●「クリーンエアフィルター プレミアム」の使用用途
◎高除塵
◎脱臭(排ガス)
◎脱臭(ペット臭)
◎脱臭(食事臭)
◎抗菌・防カビ
◎抗ウイルス
◎安定風量
◎ビタミンC放出
◎各種由来たんぱく質の減少
Amazonでも高評価*(1308個の評価中平均の星4.4)! 税込2037円で販売中!!!*
*いずれもクリーンエアフィルターの場合・2024年6月5日現在。
デンソー(DENSO) カーエアコン用フィルター クリーンエアフィルター DCC3008 (014535-2220) 高除塵 PM2.5対…

コメント
コメントの使い方